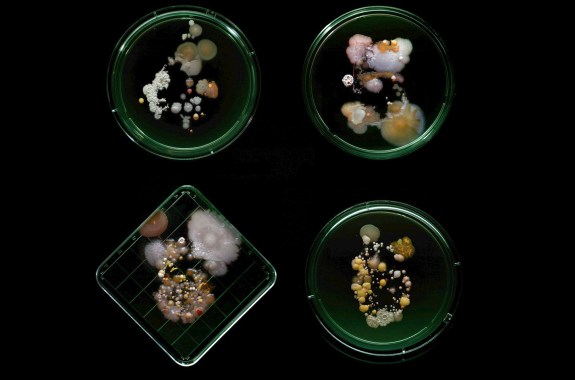
Subvisual Subway: The Art of New York City’s Bacterial World
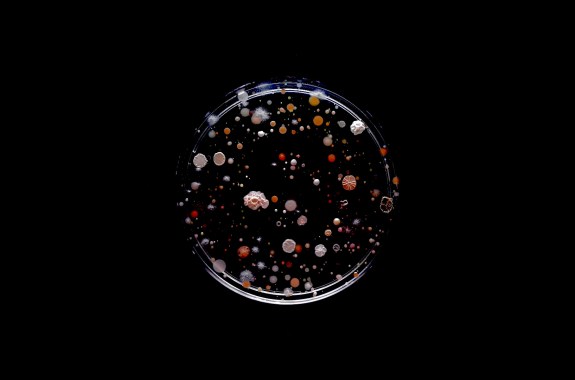
An Artist Swabs the NYC Subway

More on the Microbiome
15:26
A Microbiome Is Born
Researchers are trying to sort out what effect factors like an infant’s delivery method and early diet have on its community of microorganisms.
12:10
You’ve Heard Of The Microbiome—Welcome To The Mycobiome
Though fungi make up a tiny part of the human microbiome, they play an important role in both the prevention and development of many diseases.
Your Very Special Microbial Cloud
At the Biology and the Built Environment Center at the University of Oregon, researchers have revealed that not only can they detect and catalog the microbial cloud of someone in a room, but each person’s cloud is unique.
17:26
You Are What You Cook
How cooking your food changes your microbiome—and what that could say about human evolution.
17:35
Today, Cataloguing The Human Microbiome. Tomorrow, The World’s
What can the microbiome of Komodo dragons and coral reefs tell us about microbial life on Earth?
14:09
What Microbes Are Hiding In Your Home?
From slime in your shower head to fungi in your drywall, there’s no escaping the microbiome of the great indoors.
The Bacterium Disappearing From Our Stomachs
A primer on the gut bacterium Helicobacter pylori, and the controversy surrounding it.
10:52
A Tiny, Living Identification Badge: Your Microbiome
The specific combinations of strains of bacteria that live on and in a person can be used to identify an individual—even up to a year later.
26:29
Monster Microbiome Mash
Just in time for Halloween, scientists Rob Dunn and Amanda Hale imagine what the microbiomes of werewolves, vampires, and other monsters might entail.
Make A Home For Microbes To Understand Their Behavior
Build a home for microbes as you create a Winogradsky column, a simple ecosystem for bacteria and other microorganisms.
Subvisual Subway: The Art of New York City’s Bacterial World
Typographer and illustrator Craig Ward sampled the bacteria on subway lines around New York City and photographed his findings.
7:13
Exploring Remote Villages for Clues to the Human Microbiome
The microbes that live on and in residents of an Amazonian village with no recorded contact with Western civilization are super-diverse—and some carry genes for antibiotic resistance.
11:43
Rooting Out the Plant Microbiome
Scientists are uncovering the importance of the plant microbiome for fighting off pathogens and increasing crop yields.
12:08
Artificial Sweeteners Might Sour Your Microbiome
Researchers say artificial sweeteners may alter the microbiome and the body’s ability to control glucose levels.
10:40
A Tiny Training Partner In Your Gut?
Though the ads tell you it’s gotta be the shoes, a new study suggests that elite runners might get an extra performance boost from the microbiome.
17:17
Spilling Our Guts: Decreased Diversity in the Human Microbiome
How can hospital stays and the evolution from apes to humans change the diversity of our microbiome?
12:06
Getting To Know The Fungus Among Us (In Our Guts)
Our gut microbiome is home to fungi, too. How our immune system targets a shapeshifting yeast—to our benefit and its.
12:15
The Oldest Bird, a Distant Galaxy, and the Beard Microbiome
Rachel Feltman of The Washington Post joins us for a roundup of her top science stories this week.
22:52
Can the Bacteria in Your Gut Send Messages to Your Brain?
Researchers discuss how the microbiome might play a role in anxiety, depression, and autism.
29:51
Michael Pollan: You Are What You Cook
Pollan once advised, “Eat food. Not too much. Mostly plants.” Now, he tells us how to cook it.
6:00
An Artist Swabs the NYC Subway
An artist creates unconventional “portraits” of NYC commuters with bacteria gathered on the subway.
8:00
Can Intestinal Bacteria Shape Response to Early-Life Stress?
A new study investigates the link between the gut and the brain in mice.
Monster Microbiology, 101
If werewolves and other ghouls existed, they’d surely have microbiomes.
11:54
HIV Prevention With PrEP, an Ancient Microbiome, and Freezing Fat
A new study shows that nearly two-thirds of new HIV infections in gay and bisexual men in the Netherlands could be prevented with pre-exposure prophylaxis.
11:58
How The Microbiome Can Affect Cancer Treatments
Researchers found that patients who responded well to immunotherapy had a more diverse mix of gut bacteria.
33:23
Lactose Intolerance May Have A Lot To Do With Your Gut Microbiome
A third of the U.S. is lactose intolerant, and studying the microbiome might explain why.
Explore More
Community Science
You can do science anywhere. Learn about crowd, collaborative, community and citizen science projects for anyone to participate in!
Read More